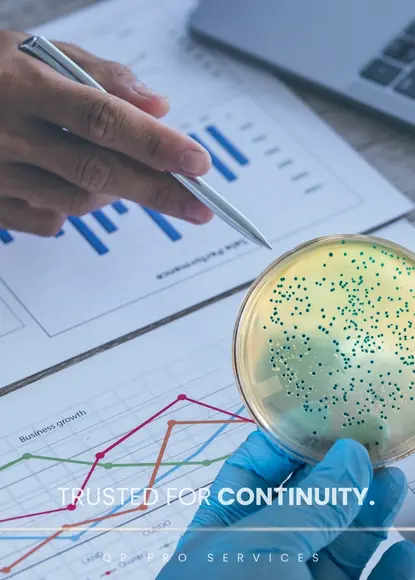

Explore our projects
Highlighted examples of our work
Advanced Data Analysis as an Enabler to Near Real-Time CCS Evaluation
Discover how data analytics and near real-time dashboards can strengthen contamination control and decision-making.
Learn more
Guiding Pharmaceutical Manufacturers in Cleanroom Glove Selection
Learn how to select cleanroom gloves that meet regulatory expectations while balancing performance, safety, and sustainability.
Learn more
Microbial Monitoring of RABS Gloves: Unravelling the Implications of Directional Use
Understand how glove usage direction impacts microbial monitoring, audit outcomes, and sterility assurance.
Learn more
Let’s join hands and make it happen with the team!
Success is never a solo journey—it’s a collective effort driven by teamwork,
collaboration, and shared vision. When we come together.








